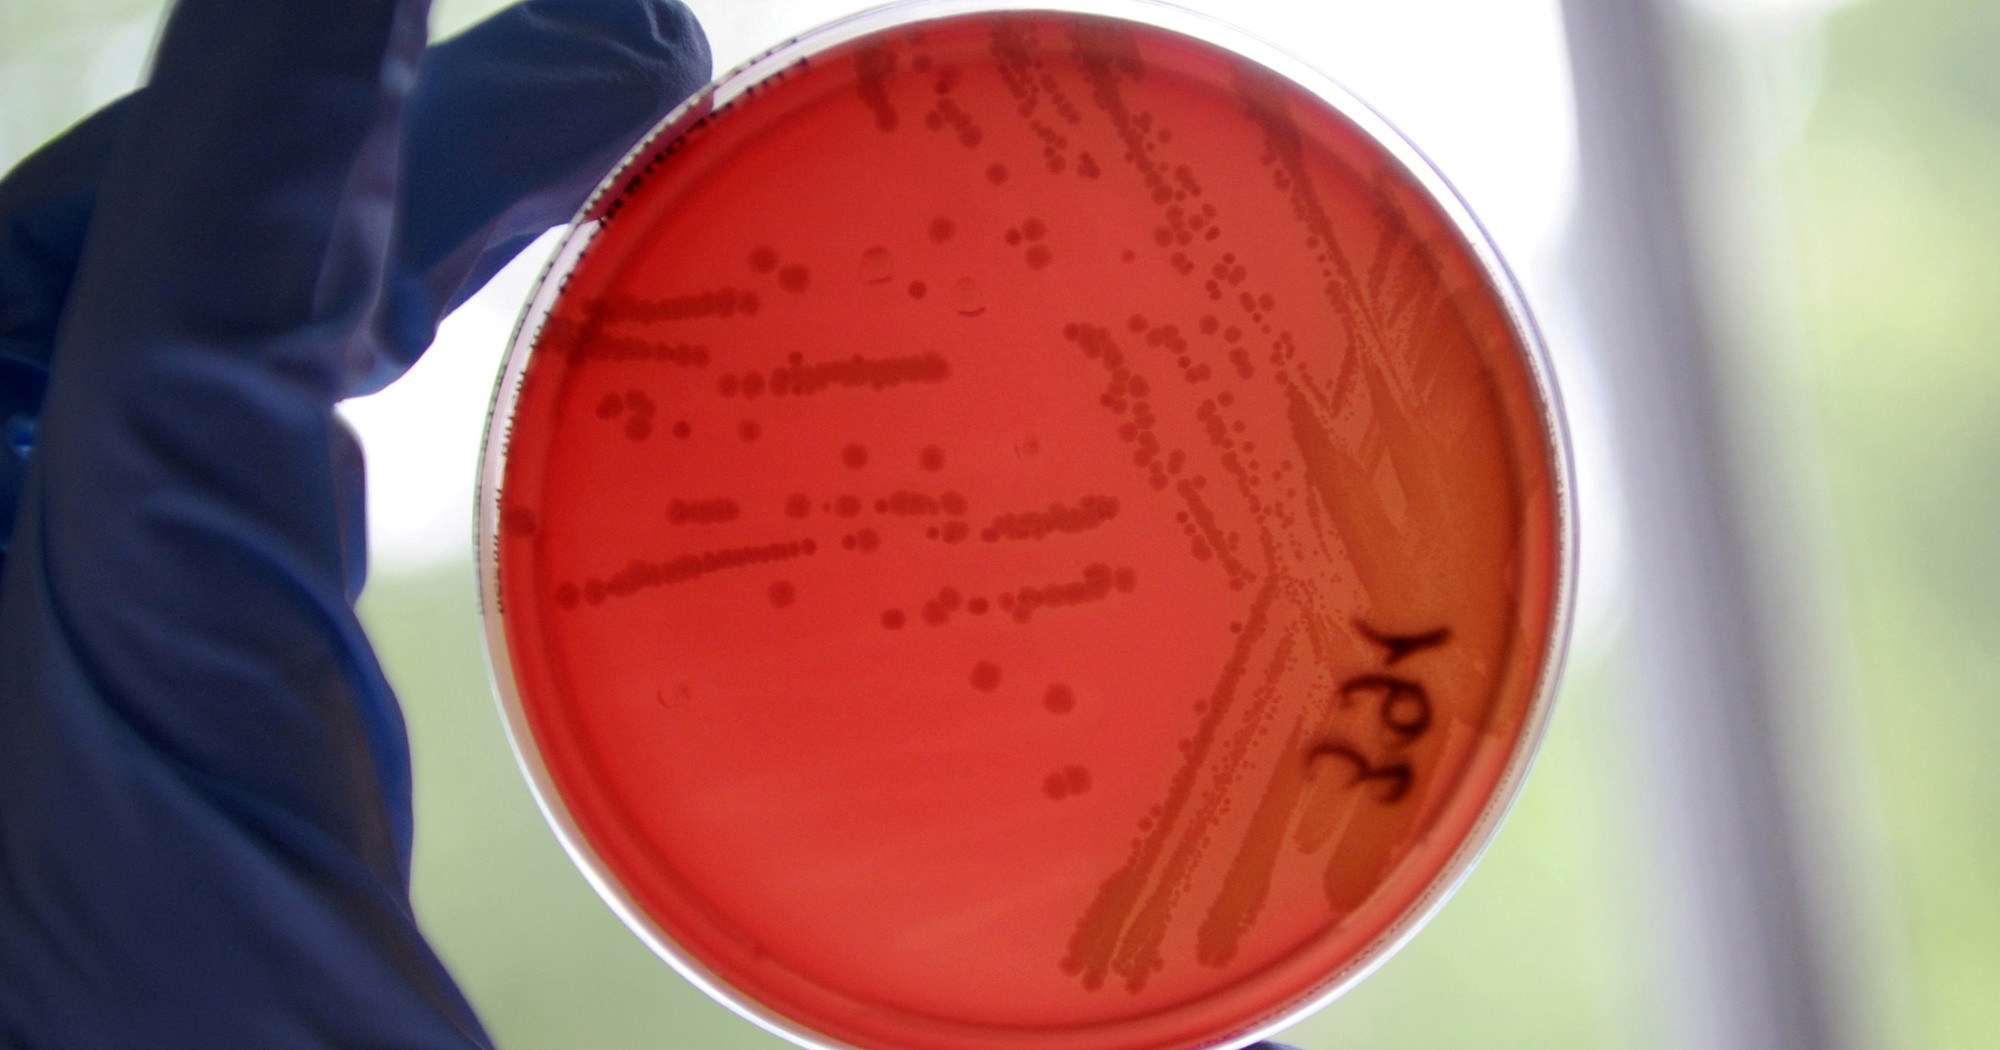
Znanstvenici u ledu otkrili soj bakterije star 5000 godina. Otporan je na antibiotike

VIDEO Grmoja Plenkoviću: Gukni, golube
MOST je održao konferenciju za medije o ogromnoj pljački Ine.
"Da vam netko kao zaposlenoj osobi uplati 50.000 kuna, netko bi vas nazvao na telefon", rekao je Petrov na početku presice.
Nešto kasnije govorio je Nikola Grmoja. Kaže da oporba nema puno mogućnosti. "Ali otvorit ćemo razgovore s ostatkom oporbe oko pokretanja istražnog povjerenstva koje bi se bavilo Inom. Ina se nije krala samo godinu dana, krade se godinama", kaže.
“Sjetite se Bijelih noći i SDP-a koji je počeo predaju Ine Mađarima. Sjetite se Ive Sanadera i predaje upravljačkih prava na koruptivan način, to je potvrdio i Vrhovni sud", rekao je. Onda je prozvao i Plenkovića.
"Nije ni čudo da nije ispoštovan dogovor o plinskom biznisu. Sustavno se radilo na tome da se Mađarska dokopa Ine, a da se naši lešinari i hijene dobro uklope", rekao je. "Možda možemo na nekakav način otvoriti pitanje ove afere na antikorupcijskom vijeću", dodao je Grmoja.
"Ljudi mi pišu 'tražite ostavku vlade'. Tražimo je cijelo vrijeme. Ovo u svakoj normalnoj državi bi značilo da premijer odlazi. Da vam u tvrtki u kojoj država ima veliko udio nestane milijardu kuna u jednoj godini, a vi ste postavili članove Uprave, značilo bi samo jedno, a to je odlazak predsjednika vlade. Imam samo jednu poruku za Andreja Plenkovića: Gukni, golube", rekao je Grmoja.

Facebook
Facebook
 Google
Google